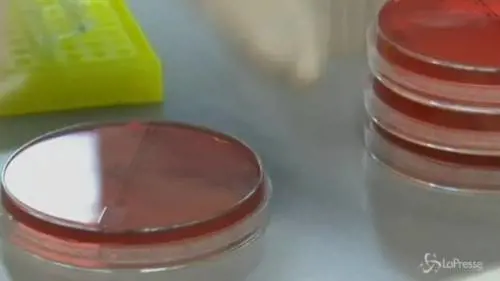
Antitrust: Multa record da 180 milioni a Roche e Novartis

La multinazionale svizzera ha strutturato un accordo per la terapia sviluppata dalla danese Zealand Pharma. L’obiettivo? Presiedere un mercato che potrebbe raggiungere i 100 miliardi di dollari entro il 20230

La multinazionale svizzera ha strutturato un accordo per la terapia sviluppata dalla danese Zealand Pharma. L’obiettivo? Presiedere un mercato che potrebbe raggiungere i 100 miliardi di dollari entro il 20230

Maxi risarcimento chiesto dal ministero della Salute a Roche e Novartis dopo il caso Avastin-Lucentis, già costato ai due colossi una multa dell’Antitrust

Il Tamiflu, che doveva servire a sconfiggere le influenze aviaria e suina, avrebbe avuto gli effetti di una normale tachipirina: ma fu pagato 3 miliardi di euro

Rifatte le tabelle sugli stupefacenti dopo la bocciatura della Fini-Giovanardi. Inserita una norma contro i trust tra aziende farmaceutiche

I due colossi farmaceutici hanno condizionato le vendite dei principali prodotti destinati alla cura della vista: avvantaggiato un farmaco più costoso

Successo della ricerca biotecnologica condotta dalla società della Fondazione Mps nella ricerca di terapie innovative per la malattia di Alzheimer.
